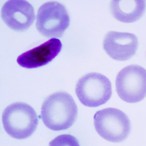

-

유한양행, 창립 100주년 기념 ..웹툰 ‘NEW 일한’ 연재
- 2026-02-28 09:57
- 김용빌 기자
-

한미 ‘아모프렐’ 3상 임상 결과, 美 심장학회 공식 저널 JACC 등재
- 2026-02-27 09:37
- 김용빌 기자
-

태극제약 ’도미나크림’, 기미·색소침착 치료제 시장서 점유율 1위 유지
- 2026-02-27 07:41
- 김용빌 기자
-

에스티젠바이오, 글로벌 본격 진출을 위한 생산설비 증설 나서
- 2026-02-27 07:36
- 김용빌 기자
-

호흡곤란과 피로감...‘이런 증상’이면 심부전 의심해야
- 2026-02-27 07:32
- 김용빌 기자
-

국제성모병원, 인천교구 청소년사목국으로부터 소아·청소년 치료비 전달받아
- 2026-02-27 07:29
- 김용빌 기자
-

KH한국건강관리협회 서울강남지부, 천연 제습제 만들기 봉사활동 참여
- 2026-02-27 07:24
- 김용빌 기자
-

충북대학교병원 충북지역암센터 ,‘간암의 날’ 기념 캠페인 및 건강강좌 개최
- 2026-02-27 07:22
- 김용빌 기자
-

한국로슈진단, 코바스 말라리아 시약 출시
- 2026-02-26 09:01
- 김용빌 기자
-
명지병원 재활의학과, ‘운동 손상 후 재활과 스포츠 복귀’ 연수강좌 개최
- 2026-02-26 08:47
- 김용빌 기자
-
씨티씨바이오, 2025년 영업이익 62억원·당기순이익 32억원 달성
- 2026-02-26 08:25
- 김용빌 기자
-

충북대학교병원 희귀유전질환센터, 희귀질환 바로알기 캠페인 개최
- 2026-02-26 06:40
- 김용빌 기자
-

영화식품 '건강즙(마가목진액)' 판매 중지 회수 조치
- 2026-02-26 06:31
- 김용빌 기자
-

동화약품, 민강 초대 사장 평전 출판기념회 개최
- 2026-02-26 06:23
- 김용빌 기자
-

구부정한 자세가 만든 척추변형, 방치하면 평생 통증
- 2026-02-25 09:30
- 김용빌 기자
-

상계백병원 척추센터 장동균 교수, 세계척추변형학회(SRS) 아시아태평양 학술대회 공동의…
- 2026-02-25 09:29
- 김용빌 기자
-

신신제약, 손·발톱 무좀 치료제 ‘무조무네일외용액’ 출시
- 2026-02-25 07:50
- 김용빌 기자
-

원광대학교병원, 모든 흉부 CT에 AI 판독 임상 정착
- 2026-02-25 07:49
- 김용빌 기자
-

한국제약바이오협회, 권기범 이사장 시대 '활짝'
- 2026-02-24 18:42
- 김용빌 기자
-

국제약품·셀트리온제약 ‘아이덴젤트’, 출시 약 1년 만에 140억원 돌파
- 2026-02-24 09:11
- 김용빌 기자
-

옷깃이 닿아도 극심한 통증, 일상적인 통증이 아닌 '이질환' 의심
- 2026-02-24 08:19
- 김용빌 기자
-

차 의과학대학교, ‘2026 포천 CEO 비즈니스 포럼’ 성료
- 2026-02-24 07:35
- 김용빌 기자
-

동아ST, 자기주식 50% 소각, 감액배당 추진… 주주환원 정책 강화
- 2026-02-24 07:30
- 김용빌 기자
-

국제약품, 히알루론산 점안액 ‘비스메드’로...서울아산병원 등 상급종합병원 처방 빠르게…
- 2026-02-23 09:24
- 김용빌 기자
- 1 셀바스AI, 아마존·바이두 협업 기반 모빌리티 AI 확대
- 2 제약협약가제도 비대위·중기중앙회 “일방적 약가인하, 제약바이오 산업 붕괴 우려”
- 3 식약처,금속성 이물 혼입된 ‘곡류가공품’ 회수 조치
- 4 위더스제약 품질관리에 무슨일이...식약처,‘위더셋정’ 불순물 초과 검출 우려 회수 조치
- 5 식약처, 강황추출물 등 기능성 원료 재평가…인정 취소·섭취기준 조정 가능
- 6 노재영칼럼/ 약가 인하의 파장, 경영의 고민을 넘어 노동의 불안으로
- 7 노재영 칼럼/ “고통의 벽을 낮춘 한 걸음”…CRPS 환자들이 환영한 식약처의 적극 행정
- 8 식약처,알레르기 유발물질 미표시 ‘초콜릿가공품’ 회수 조치
- 9 식약처·지재처·관세청, ‘위조 화장품’ 범부처 대응 나선다
- 10 질병관리청, 국장급 승진 및 과장급 전보 인사